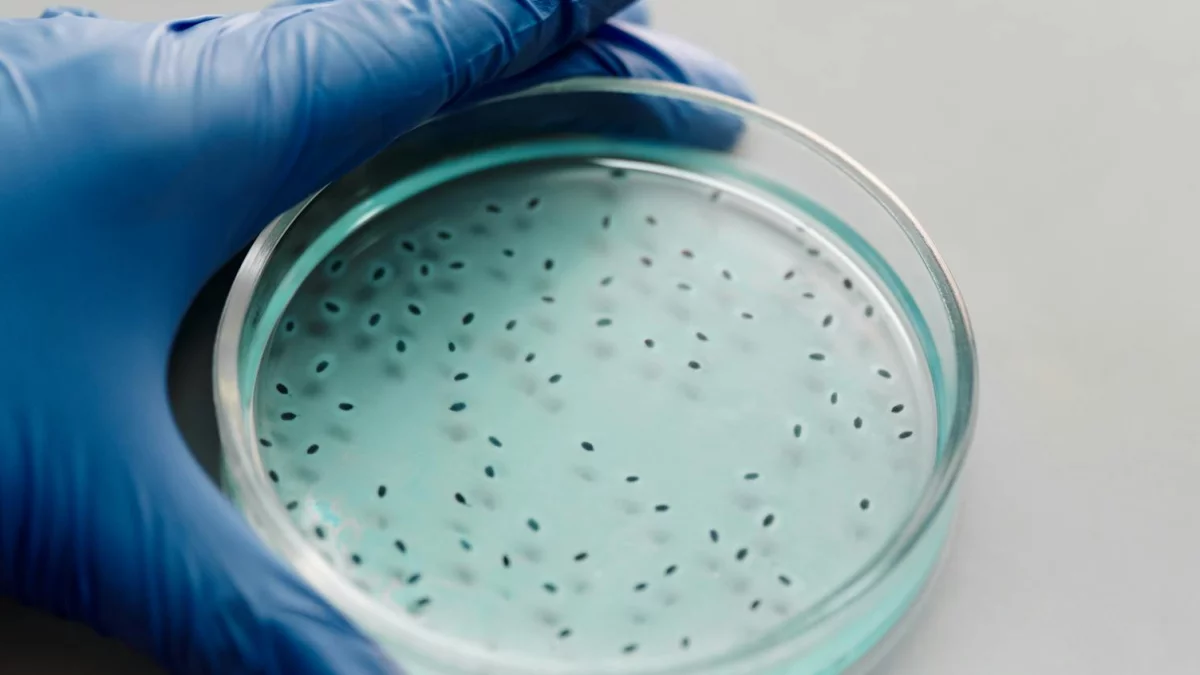

Czym jest Helicobacter pylori?
Helicobacter pylori to gram-ujemna bakteria o kształcie helikalnym, głównie zasiedlająca błonę śluzową żołądka, zwłaszcza w części przedodźwiernikowej oraz w odźwierniku. Może także zakażać dwunastnicę, pozostając istotnym czynnikiem chorobotwórczym w układzie pokarmowym. Jej zdolność do przeżywania w kwaśnym środowisku żołądka wiąże się z produkcją enzymu ureazy, który neutralizuje kwas żołądkowy.
Bakterię tę odkryli w 1982 roku australijscy naukowcy Marshall i Warren, co diametralnie zmieniło sposób rozumienia przyczyn wielu dolegliwości przewodu pokarmowego. H. pylori uznaje się za czynnik sprzyjający powstawaniu nowotworów żołądka.
Jakie jest rozpowszechnienie zakażenia Helicobacter pylori?
Szacuje się, że prawie połowa ludzi na świecie jest zakażona Helicobacter pylori, przy czym infekcje zdarzają się częściej w krajach rozwijających się. W Polsce bakterią tą zarażonych jest 67% dorosłych oraz 30% dzieci, choć ostatnio obserwujemy tendencję spadkową. Nosicielami bywa nawet 70-80% dorosłych Polaków, co tylko podkreśla powszechność tego zakażenia.
Często przebiega ono bezobjawowo, co utrudnia diagnozowanie i sprzyja powstawaniu powikłań. Warto podkreślić, że tylko u niewielkiej części zakażonych rozwijają się choroby powiązane z obecnością tej bakterii.
Związek Helicobacter pylori z chorobami przewodu pokarmowego
Helicobacter pylori odpowiada za około 80% przypadków choroby wrzodowej żołądka oraz 90% wrzodów dwunastnicy. Zakażenie nią to także najczęstsza przyczyna przewlekłego zapalenia błony śluzowej żołądka. Co więcej, H. pylori bywa czynnikiem prowadzącym do raka żołądka i chłoniaka żołądka, działając jako promotor nowotworu.
Jednak tylko u około co dziesiątej zakażonej osoby rozwinie się choroba wrzodowa, a 10-20% nosicieli doświadcza dolegliwości. U większości z nich choroba się nie ujawnia, a przyczyny tego zjawiska nie są do końca wyjaśnione.
Mechanizm działania i objawy zakażenia
- pylori uszkadza komórki nabłonka żołądka, produkując szkodliwe związki, takie jak amoniak, proteazy, cytotoksyne A czy fosfolipazy. Enzym ureaza, który wytwarza, pozwala jej przetrwać w kwaśnym środowisku żołądka.
Najczęstsze objawy zakażenia, choć nie zawsze się pojawiające, to:
- Wzdęcia i obrzęk brzucha,
- Ból brzucha nasilający się po posiłku,
- Zgaga i pieczenie za mostkiem,
- Zmiany w wypróżnianiu, takie jak naprzemienne biegunki i zaparcia.
Warto zaznaczyć, że samo zakażenie nie musi prowadzić do pojawienia się objawów czy rozwoju choroby, a samowyleczenie zdarza się rzadko – częściej infekcja przechodzi w postać przewlekłą.
Diagnostyka i leczenie zakażenia Helicobacter pylori
Diagnostyka zakażenia H. pylori wykorzystuje zarówno metody inwazyjne, jak test ureazowy i badania histologiczne, jak i nieinwazyjne – testy oddechowe, wykrywanie antygenów w kale oraz testy serologiczne. W Polsce na pierwszym miejscu stoi poczwórna terapia z bizmutem, której celem jest całkowite wyeliminowanie bakterii z organizmu.
W jej skład wchodzą zwykle dwa antybiotyki na helicobacter (najczęściej amoksycylina oraz klarytromycyna lub metronidazol), inhibitor pompy protonowej oraz preparat bizmutu. Zastosowanie antybiotyków ma kluczowe znaczenie, ponieważ hamują one wzrost i namnażanie bakterii, umożliwiając ich całkowitą eradykację, jednak skuteczność leczenia może być ograniczona przez narastającą oporność H. pylori na niektóre z tych leków.